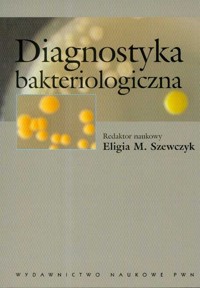
Diagnostyka bakteriologiczna -  - książka

Kategorie
- Wszystkie
- Kryminał
- Fantastyka
- Thriller, sensacja, horror
- Literatura obyczajowa i piękna
- Romanse i erotyka
- Powieści przygodowe i historyczne
- Literatura faktu
- Dla dzieci
- Dla młodzieży
- Biznes, rozwój, prawo
- Literatura popularnonaukowa
- Poradniki
- Religia i duchowość
- Czasopisma
- Lektury
- Poezja i dramat
- Języki obce
- Poradniki do gier
- Komiksy
- Atlasy i albumy
- Darmowe
Sortuj według: